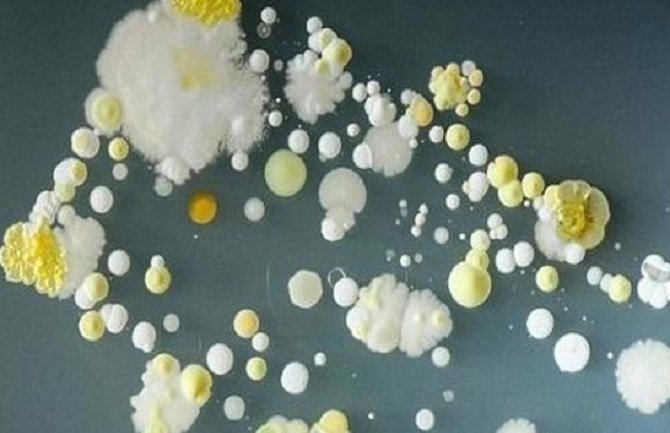
Dokazano da je telefon leglo bakterija

U mnogim slučajevima bakterije su uglavnom bezopasne i dolaze sa nečistih površina ili prljavih ruku korisnika. Ali, ponekad bakterije mogu izazvati infekcije kao što je trovanje hranom.
Studenti sa Univerziteta u Surreyju su u cilju spoznaje o stvarnoj prirodi površine modernih telefona, svoje smartphone uronili u posebne posude sa tečnošću koja pospješuje razvoj bakterija.
Jednom kada su u njih stavili svoje telefone, bakterije su prešle u posudu i počele se razmnožavati. Test je trajao tri dana i rezultat je bio više nego šokantan.
Na telefonima je otkrivena bakterija Staphylococcus aureus, koja izaziva infekciju kože. Ljudi nose ove bakterije bez bojazni da će oboljeti, ali ukoliko je koža povrijeđena može doći do ulaska bakterije u ranu, koja potom uzrokuje infekciju.
Druga bakterija koja je primijećena je Bacillus mycoides, a ona se u laboratorijama koristi za ubrzanje rasta drugih opasnih bakterija i gljivica.
(klix.ba)

Komentari